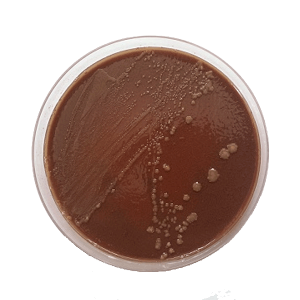
CEM Outbreak - Chocolate Eugon - Prepared Culture Media For Taylorella Equigenitalis showing growth

US CEM Outbreak – Update
The CEM outbreak in Florida continues to produce new cases. The initial animal was a mare identified following breeding in May. Tracebacks commenced and to date there are a total of 43 cases, which include 16 domestic ponies (2 stallions, 1 mare, and 13 geldings), 14 riding horses of various breeds (all geldings), and 13 draft horses (all geldings). These are all connected to a single farm in Orange County, Florida. Forty (40) of the positive horses are located on the index farm in Florida and 3 positive geldings are trace outs from the index farm which are quarantined on two other farms in Florida and one farm in North Carolina. These figures are current as of 9/20/2024.
The first positive pony stallion was traced back to a farm of origin in Polk County, Missouri, where he was foaled in 2021 and remained until August 2023. His dam, a pony mare, was the only potentially exposed horse on the premises and has completed testing with all negative results. The second positive pony stallion was traced back to a farm of origin in Gallatin County, Kentucky, where he was born into an owned, but essentially feral herd of about a dozen domestic ponies and donkeys which were dispersed in 2022. Results of the epidemiologic investigation to date indicate that neither infected pony stallion was likely to have been the source of the outbreak. Traceback of each infected gelding will be conducted to evaluate the potential of each horse to have been the source of infection on the index farm.
A veterinary hospital in Florida participated in collection and handling of one of the infected pony stallions from 2022-2024. The hospital’s resident stallion was identified as potentially exposed through shared semen collection equipment and has completed testing with all negative results. A client stallion collected by the hospital using equipment shared with the infected pony stallion in 2022 and 2024 has also been identified as exposed and is currently undergoing testing with negative results to date.
Trace out information was obtained for all horses potentially exposed that left the index premises in Florida from 2022 to 2024. A total of 18 horses (all geldings) were located and quarantined for testing in 8 states (Florida, Georgia, Illinois, Iowa, Maine, Maryland, Michigan, and North Carolina). On September 18th and 19th, NVSL reported confirmation of T. equigenitalis-infection on the initial samples of 3 of the trace out horses, 2 geldings located on separate farms in Florida and 1 gelding on a farm in North Carolina. Testing of the other exposed trace out horses is ongoing and the positive horses are being scheduled for treatment.
The situation is ongoing.
Source: https://www.aphis.usda.gov/livestock-poultry-disease/equine/contagious-equine-metritis